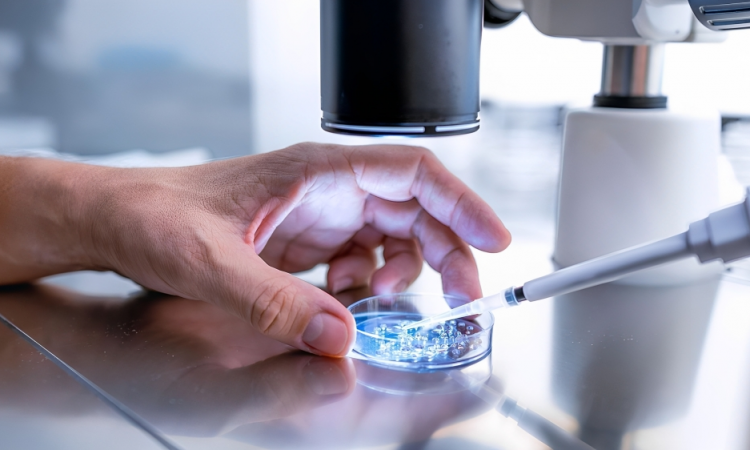

Científicos crean embriones humanos a partir de células de piel en avance histórico
Estados Unidos. – Científicos de la Universidad de Salud y Ciencias de Oregón han logrado crear por primera vez embriones humanos en etapas tempranas mediante la manipulación de ADN extraído de células cutáneas y su posterior fecundación con esperma, en un avance que podría revolucionar el tratamiento de la infertilidad y permitir que parejas del mismo sexo tengan hijos genéticamente emparentados.
El profesor Shoukhrat Mitalipov, director del centro de terapia génica y de células embrionarias de la universidad y líder de la investigación, afirmó que «logramos algo que se creía imposible». La técnica, publicada en Nature Communications, consiste en extraer el núcleo de una célula de la piel -que contiene todo el código genético necesario- e insertarlo en un óvulo de donante al que se le han removido las instrucciones genéticas originales, en un proceso similar al utilizado para clonar a la oveja Dolly en 1996.
El estudio demostró que, de los 82 óvulos funcionales creados mediante este método, algunos progresaron hasta las primeras etapas del desarrollo embrionario tras ser fecundados con esperma, aunque ninguno se desarrolló más allá de los seis días. La profesora Paula Amato, coautora del estudio, destacó que «además de ofrecer esperanza a millones de personas con infertilidad por falta de óvulos o espermatozoides, este método permitiría a las parejas del mismo sexo tener un hijo genéticamente relacionado con ambos miembros de la pareja».
Los investigadores reconocen que la técnica requiere perfeccionamiento significativo, con una tasa de éxito actual del 9% y desafíos técnicos como la selección aleatoria de cromosomas durante el proceso. El profesor Mitalipov advirtió que «tenemos que perfeccionarlo» y estimó que podría pasar una década antes de que alguna clínica de fertilidad considere su uso.
Expertos internacionales como el profesor Roger Sturmey de la Universidad de Hull enfatizaron que «esta investigación refuerza la importancia de un diálogo abierto y continuo con el público sobre los nuevos avances en la investigación reproductiva», mientras que el profesor Richard Anderson de la Universidad de Edimburgo calificó la capacidad de generar nuevos óvulos como «un gran avance» que ayudaría a muchas mujeres a tener sus propios hijos genéticos.
Con información de BBCnews